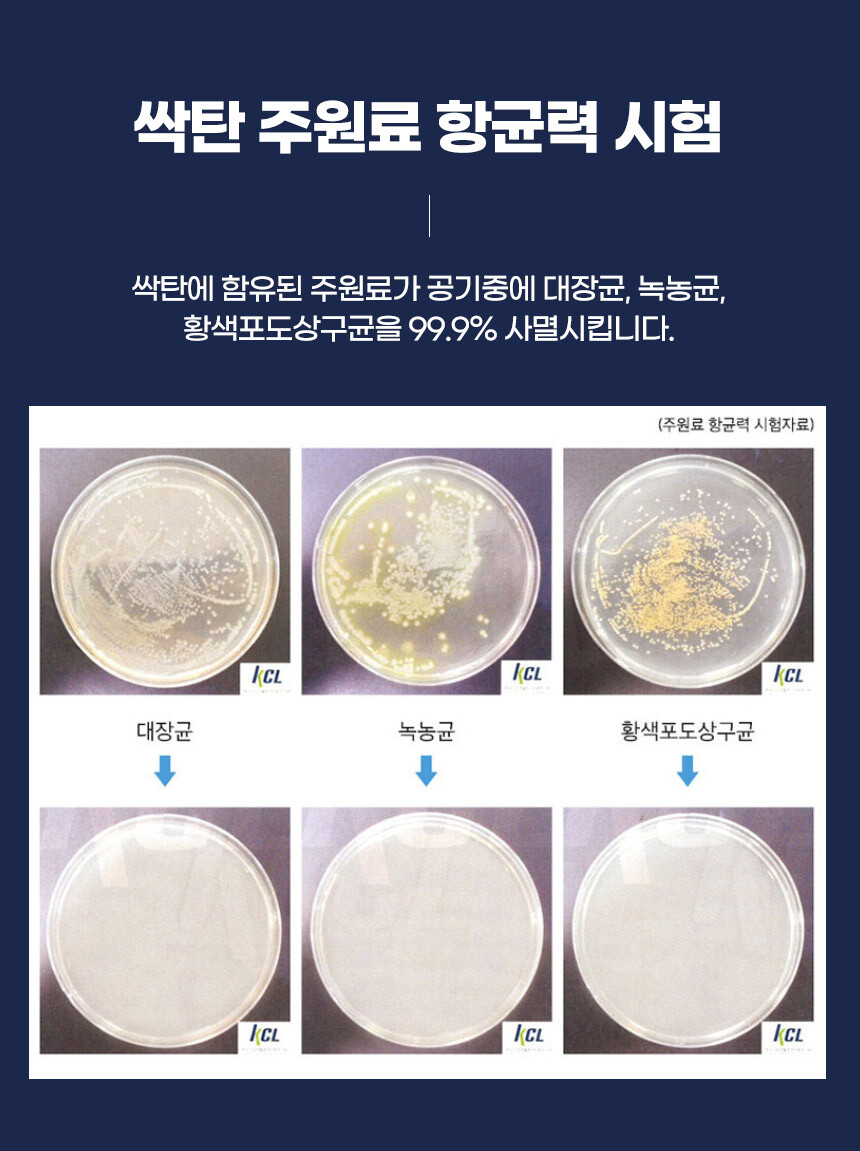

의류제품은 정식 통관을 거쳐
수입된 제품으로
가품일시 100%보상해 드립니다.
🔻🔻🔻🔻🔻🔻🔻🔻
우측하단버튼을 통해, "카톡 채널추가"를 하시면,
공구기간 놓치지 않도록 알림해드립니다.
뷰티/건강식품 전문 공동구매몰
더드리는더드림샵입니다.
. . .


✨싹탄탈취제 6종✨
사무실 각종 냄새, 화장실냄새, 음식물 쓰레기 조리 냄새까지
싹탄 탈취제로 싹~ 없애주세요
✔️싹탄에 함유된 주원료가
공기중 대장균, 녹농균, 황색포도상구균을 99.9% 사멸
✔️탈취력 95% 탈취 시험성적 완료
✔️모든컬러 식용색소, 식용응고제 사용
✔️5가지 의 자연의 향을 선택해보세요~
(아카시아향, 무향, 플라워 블랙체리 스트러스 피톤치트)
✔️캔들 워머와 함께 사용하시면 더욱 빠른 탈취 가능
✔️강력탈취제 컬러 대용량도 출시!!
✔️KCL 확인검사 적합 판정

📍공구구성
싹탄 탈취제 360g
시트러스/피톤치드/블랙체리/무향/플라워/아카시아
정상가 24,800원
공구가 13,900원
🔻네이버스마트스토어 구매는🔻
업뎃예정입니다.
어디서도 볼 수 없는 공구!
좋은제품, 최저가 공동구매는
더드리는더드림샵에서!
* 공동구매 진행은 발주서가 한번에 넘어가는 시스템이기 때문에 중간 취소시에는 제품 발송 후에 반품으로 처리가 복잡합니다.
(주문 취소는 고객님의 변심으로 진행되는 부분이라 반품택배비가 부과될 수 있으니 신중하게 구매해 주시기 바랍니다ㅠㅠ)

<더드림샵 안내드려요>
배송기간공지
발주확인 이후 12시전 주문건은 당일출고
그이후 익일출고(주말제외)드리며
주문후 2일에서 7일안에 배송드립니다.
(공구중인 일부품목은 오전 10시 마감)
환불정책
제품의 불량의 경우 교환 및, 환불 가능
불량 반품이외의 단순 변심이나 주문착오시
재판매가 불가하게 상품이 손상된 경우 교환 및 환불이 어렵습니다.
그외 상품의 사용흔적이 없이 패키지 손상이 없는경우 문의주시면
수령후 7일이내 교환, 환불이 가능합니다.
(특성상 생무은 제외되며 배송비가 추가 발생될 수 있습니다.)
* 배송문의 및 궁금하신 사항은
더드림샵 고객센터 1670-3356 이나
010-5673-3356 (문자가능) 으로 연락주세요.
우측하단의 톡하기로 주시면 더 빠르게 답변드릴게요!!!
싹탄 강력 탈취제